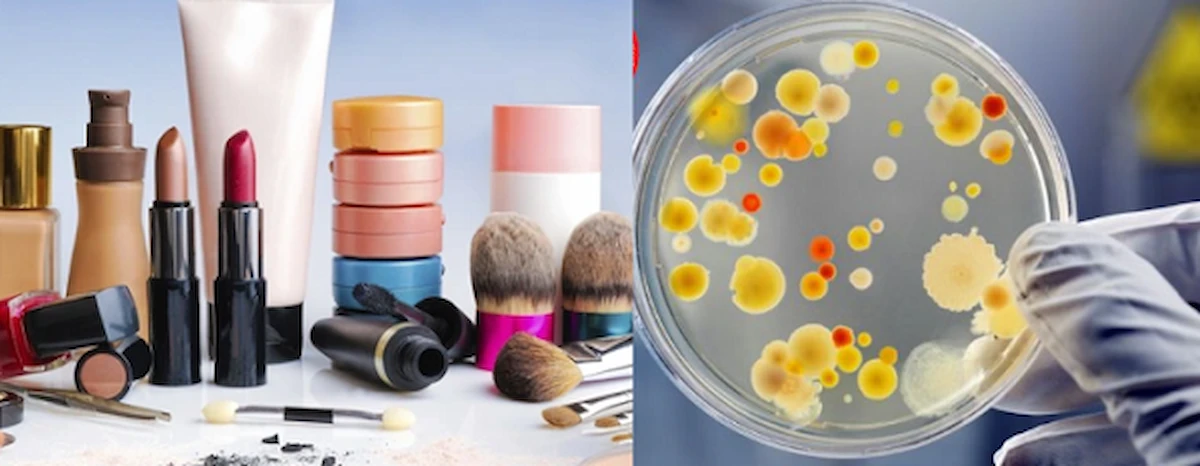
Tiêu chuẩn nước sản xuất mỹ phẩm

Bạn có bao giờ tự hỏi vì sao cùng một công thức nhưng chất lượng mỹ phẩm giữa các nhà máy lại có sự khác biệt rõ rệt? Một trong những yếu tố tạo nên sự chênh lệch ấy chính là tiêu chuẩn nước sản xuất mỹ phẩm – nền tảng quyết định độ an toàn và độ ổn định của mỗi sản phẩm. Bước sang năm 2025, những yêu cầu liên quan đến nước theo GMP, ISO 22716 và Dược điển đã có nhiều cập nhật quan trọng mà doanh nghiệp cần lưu ý. Bài viết này sẽ giúp bạn nắm rõ các quy định mới nhất và cách đảm bảo hệ thống nước luôn vận hành đúng chuẩn. Cùng theo dõi để tránh những sai sót không đáng có trong quá trình sản xuất.
1. Tổng quan về vai trò của nước trong sản xuất mỹ phẩm
Trong ngành công nghiệp mỹ phẩm, nước không đơn thuần là một chất lỏng trong suốt. Nó đóng vai trò đa diện và không thể thay thế, ảnh hưởng trực tiếp đến mọi khía cạnh của sản phẩm cuối cùng.
- Dung môi chính: Nước là nền tảng của hầu hết các sản phẩm dạng lỏng và nhũ tương như kem dưỡng, lotion, toner, serum, chiếm từ 60% đến hơn 90% công thức. Chất lượng của dung môi này sẽ quyết định khả năng hòa tan và phân tán đồng đều các hoạt chất khác.
- Thành phần hoạt chất: Trong nhiều trường hợp, nước tham gia trực tiếp vào các phản ứng hóa học, tạo nên cấu trúc gel, nhũ tương và quyết định cảm quan của sản phẩm khi thoa lên da.
- Ảnh hưởng đến độ ổn định: Một chất lượng nước trong sản xuất mỹ phẩm không đảm bảo có thể chứa các ion kim loại (như Sắt, Đồng, Magie) gây xúc tác cho quá trình oxy hóa, làm sản phẩm nhanh chóng biến đổi màu sắc, mùi hương và phân hủy hoạt chất.
- Ảnh hưởng đến độ an toàn: Đây là vai trò tối quan trọng. Nước chưa qua xử lý là môi trường lý tưởng cho vi sinh vật, nấm men, nấm mốc phát triển. Sự hiện diện của chúng trong sản phẩm có thể gây kích ứng da, viêm nhiễm, mụn trứng cá và các vấn đề da liễu nghiêm trọng cho người tiêu dùng.
- Ảnh hưởng đến hiệu quả: Các tạp chất trong nước có thể tương tác hóa học với các hoạt chất chính (như Vitamin C, Retinoids) hoặc chất bảo quản, làm giảm hoặc vô hiệu hóa tác dụng của chúng, khiến sản phẩm không mang lại hiệu quả như mong đợi.

Tổng quan về vai trò của nước trong sản xuất mỹ phẩm
2. Các tiêu chuẩn nước sản xuất mỹ phẩm mới nhất hiện nay
Để đảm bảo chất lượng và an toàn, ngành công nghiệp mỹ phẩm toàn cầu phải tuân thủ các quy định nghiêm ngặt về nguồn nước. Đây là những yêu cầu về nước trong sản xuất mỹ phẩm mà mọi doanh nghiệp cần nắm vững.
2.1. Tiêu chuẩn GMP (Good Manufacturing Practices)
GMP coi nước là một nguyên liệu thô, do đó nó phải được kiểm soát chặt chẽ như bất kỳ thành phần nào khác trong công thức. Tiêu chuẩn cGMP (Current Good Manufacturing Practices) và các hướng dẫn liên quan yêu cầu nước sử dụng phải đạt các chỉ tiêu cụ thể:
- Vi sinh vật: Đây là chỉ tiêu quan trọng bậc nhất.
- Tổng số vi khuẩn hiếu khí (Total Aerobic Microbial Count - TAMC): Phải dưới 100 CFU/ml.
- Tổng số nấm men và nấm mốc (Total Yeast and Mold Count - TYMC): Phải dưới 10 CFU/ml.
- Không được có sự hiện diện của các vi sinh vật gây bệnh nguy hiểm như Escherichia coli (E. coli), Pseudomonas aeruginosa, Staphylococcus aureus, và Candida albicans.
- Hóa lý:
- Độ dẫn điện của nước sản xuất mỹ phẩm: Một chỉ số đo lường tổng lượng ion hòa tan, phản ánh độ tinh khiết của nước.
- TOC (Total Organic Carbon): Đo lường tổng lượng carbon hữu cơ, là "thức ăn" cho vi sinh vật phát triển.
- pH: Phải nằm trong ngưỡng trung tính để không ảnh hưởng đến độ ổn định của công thức.
- Hàm lượng ion kim loại nặng (Chì, Asen, Thủy ngân...): Phải ở mức cực thấp hoặc không thể phát hiện.

Tiêu chuẩn GMP cho ngành mỹ phẩm
2.2. Tiêu chuẩn ISO 22716:2007 (Mỹ phẩm – Thực hành sản xuất tốt)
ISO 22716 là tiêu chuẩn quốc tế cụ thể hóa các nguyên tắc GMP cho ngành mỹ phẩm. Đối với nước, tiêu chuẩn này yêu cầu:
- Hệ thống nước: Phải có một hệ thống xử lý nước cho nhà máy mỹ phẩm được thiết kế, lắp đặt, thẩm định (validation), vận hành và bảo trì một cách khoa học. Hệ thống đường ống phải được làm từ vật liệu trơ (như thép không gỉ 316L), thiết kế không có "điểm chết" (dead leg) để ngăn ngừa sự hình thành màng sinh học (biofilm).
- Chất lượng nước: Phải xác định rõ cấp độ chất lượng nước cần thiết cho từng loại sản phẩm và đảm bảo hệ thống cung cấp được nước tinh khiết sản xuất mỹ phẩm một cách ổn định.
- Giám sát và tài liệu: Toàn bộ quá trình từ xử lý, lưu trữ đến phân phối nước phải được giám sát liên tục và ghi chép đầy đủ để phục vụ cho việc truy xuất nguồn gốc và kiểm tra chất lượng.

Tiêu chuẩn chất lượng mỹ phẩm toàn toàn cầu ISO 22716:2007
2.3. Các tiêu chuẩn dược điển (USP, EP) và yêu cầu cụ thể
Do yêu cầu về độ tinh khiết và an toàn ngày càng cao, nhiều nhà sản xuất mỹ phẩm, đặc biệt là dược mỹ phẩm, đã áp dụng các tiêu chuẩn của Dược điển Hoa Kỳ (USP) hoặc Dược điển Châu Âu (EP).
- Nước tinh khiết (Purified Water - PW): Đây là cấp độ phổ biến nhất được yêu cầu. Theo dược điển USP, nước tinh khiết phải đáp ứng các chỉ tiêu nghiêm ngặt:
- Độ dẫn điện: < 1.3 µS/cm tại 25°C.
- TOC: < 500 ppb (phần tỷ).
- Giới hạn vi sinh: < 100 CFU/ml.
- Nước cất pha tiêm (Water for Injection - WFI): Yêu cầu cao hơn, thường dùng cho các sản phẩm vô trùng hoặc tiếp xúc với vùng da nhạy cảm cao. Ngoài các tiêu chuẩn của PW, WFI còn phải đáp ứng yêu cầu về Nội độc tố vi khuẩn (Bacterial Endotoxins) < 0.25 EU/ml.
3. Quy trình và công nghệ xử lý nước đạt chuẩn cho ngành mỹ phẩm
Để đạt được các tiêu chuẩn nước sản xuất mỹ phẩm khắt khe nêu trên, một hệ thống xử lý nước hoàn chỉnh và hiện đại là điều kiện bắt buộc.
3.1. Các giai đoạn xử lý nước cơ bản
Một hệ thống RO cho mỹ phẩm điển hình bao gồm các giai đoạn:
- Tiền xử lý (Pre-treatment): Loại bỏ các tạp chất thô để bảo vệ các màng lọc tinh phía sau. Bao gồm: lọc đa tầng (loại bỏ cặn lơ lửng), lọc than hoạt tính (hấp thụ clo, chất hữu cơ, mùi, màu).
- Khử khoáng (Demineralization): Giai đoạn cốt lõi để loại bỏ các ion hòa tan, giảm độ dẫn điện. Công nghệ phổ biến nhất là Thẩm thấu ngược (RO).
- Khử trùng (Disinfection): Tiêu diệt hoặc bất hoạt vi sinh vật còn sót lại. Thường sử dụng đèn UV (tia cực tím) hoặc sục khí Ozone.
- Đánh bóng (Polishing): Giai đoạn cuối cùng để đạt độ tinh khiết siêu cấp, thường sử dụng công nghệ EDI (Electrodeionization) hoặc cột trao đổi ion hỗn hợp (Mixed-bed).
3.2. Công nghệ xử lý nước tiên tiến
- Hệ thống thẩm thấu ngược (Reverse Osmosis - RO): Sử dụng màng bán thấm với kích thước lỗ lọc siêu nhỏ (cỡ 0.0001 micron) để loại bỏ 99% các ion hòa tan, vi khuẩn, virus và các phân tử hữu cơ. Đây là trái tim của hệ thống nước đạt chuẩn GMP mỹ phẩm.
- Hệ thống EDI (Electrodeionization): Là công nghệ kết hợp giữa trao đổi ion và dòng điện, giúp loại bỏ triệt để các ion còn lại sau RO để đạt độ dẫn điện cực thấp. Ưu điểm vượt trội của EDI là hoạt động liên tục và không cần sử dụng hóa chất để tái sinh, giảm chi phí vận hành và thân thiện với môi trường.
- Hệ thống UV (Ultraviolet): Chiếu tia cực tím ở bước sóng 254nm để phá hủy DNA của vi sinh vật, ngăn chúng sinh sản. Đây là phương pháp khử trùng an toàn, hiệu quả, không làm thay đổi tính chất hóa lý của nước.

Công nghệ RO xử lý nước đạt chuẩn GMP mỹ phẩm
3.3. Hệ thống giám sát và kiểm soát chất lượng nước
Một hệ thống hoàn chỉnh không chỉ xử lý mà còn phải giám sát liên tục. Các cảm biến đo độ dẫn điện, TOC, nhiệt độ, lưu lượng được lắp đặt online để theo dõi chất lượng nước 24/7. Hệ thống đường ống tuần hoàn và các quy trình vệ sinh tự động CIP (Clean-in-Place) / SIP (Sterilize-in-Place) là bắt buộc để đảm bảo chất lượng nước đầu vào cho mỹ phẩm luôn được duy trì ở mức cao nhất.
4. Hậu quả của việc không tuân thủ tiêu chuẩn nước
Việc xem nhẹ hoặc bỏ qua các quy định về nước dùng trong mỹ phẩm sẽ dẫn đến những hậu quả nghiêm trọng và đa chiều:
- Rủi ro an toàn sản phẩm: Gây ra các vấn đề từ kích ứng nhẹ đến nhiễm trùng da nặng cho người tiêu dùng.
- Mất ổn định sản phẩm: Sản phẩm bị biến màu, tách lớp, thay đổi mùi, giảm đáng kể thời hạn sử dụng.
- Thiệt hại kinh tế: Chi phí thu hồi toàn bộ lô hàng, bồi thường cho người tiêu dùng, và mất doanh thu trực tiếp.
- Sụp đổ uy tín thương hiệu: Niềm tin của khách hàng là tài sản quý giá nhất. Một vụ bê bối về chất lượng có thể phá hủy hình ảnh thương hiệu đã xây dựng trong nhiều năm.
- Vi phạm pháp luật: Đối mặt với các án phạt hành chính nặng, đình chỉ sản xuất, thậm chí là truy tố hình sự.
Hậu quả của việc không tuân thủ tiêu chuẩn nước
5. Địa chỉ thiết kế & bảo trì hệ thống xử lý nước mỹ phẩm uy tín

Địa chỉ thiết kế & bảo trì hệ thống xử lý nước mỹ phẩm uy tín
Tại Công Nghệ Thiết Bị Lọc Miền Nam, chúng tôi không chỉ cung cấp thiết bị, chúng tôi mang đến một giải pháp xử lý nước toàn diện, được thiết kế riêng để đáp ứng những tiêu chuẩn nước sản xuất mỹ phẩm khắt khe nhất.
Với vai trò là chuyên gia trong lĩnh vực, chúng tôi cung cấp:
- Tư vấn và thiết kế: Ngay khi nhận được yêu cầu, đội ngũ kỹ thuật viên của chúng tôi sẽ có mặt tại nhà máy của bạn để khảo sát miễn phí toàn diện hệ thống, kiểm tra chi tiết các thông số vận hành, phân tích chất lượng nguồn nước và đánh giá yêu cầu sản xuất. Từ đó, chúng tôi đề xuất phương án thiết kế hệ thống tối ưu nhất, bảo đảm tuân thủ tuyệt đối các tiêu chuẩn GMP, ISO 22716 và Dược điển.
- Cung cấp và lắp đặt: Cung cấp các thiết bị và công nghệ xử lý nước mỹ phẩm tiên tiến nhất thế giới như RO, EDI, UV, UF từ các thương hiệu uy tín.
- Bảo trì và thẩm định: Cung cấp dịch vụ bảo trì định kỳ, hiệu chuẩn thiết bị và hỗ trợ thực hiện các hồ sơ thẩm định hệ thống (IQ, OQ, PQ) để đáp ứng yêu cầu của cơ quan quản lý.
- Đào tạo và chuyển giao: Hướng dẫn vận hành chi tiết, chuyển giao công nghệ để đội ngũ của bạn có thể tự chủ trong việc kiểm soát hệ thống.
Chúng tôi cam kết đồng hành cùng bạn, đảm bảo nguồn nước đầu ra không chỉ đạt chuẩn mà còn vượt chuẩn, giúp bạn tự tin sản xuất những sản phẩm an toàn, chất lượng và chinh phục những thị trường khó tính nhất.
Tóm lại, việc đầu tư và tuân thủ nghiêm ngặt các tiêu chuẩn nước sản xuất mỹ phẩm không phải là một chi phí, mà là một khoản đầu tư chiến lược vào sự an toàn của sản phẩm, uy tín của thương hiệu và sự phát triển bền vững của doanh nghiệp. Một hệ thống xử lý nước chất lượng cao chính là nền tảng vững chắc để tạo ra những sản phẩm mỹ phẩm ưu việt.
Để tìm hiểu sâu hơn về cách xây dựng một hệ thống xử lý nước đạt chuẩn GMP cho nhà máy của mình, bạn có thể tham khảo thêm các bài viết chuyên sâu của chúng tôi về thẩm định hệ thống nước hoặc liên hệ trực tiếp để nhận được sự tư vấn từ các chuyên gia hàng đầu.
__________________________
𝑪𝒐̂𝒏𝒈 𝑵𝒈𝒉𝒆̣̂ 𝑻𝒉𝒊𝒆̂́𝒕 𝑩𝒊̣ 𝑳𝒐̣𝒄 𝑴𝒊𝒆̂̀𝒏 𝑵𝒂𝒎 - 𝑮𝒊𝒂̉𝒊 𝑷𝒉𝒂́𝒑 𝑪𝒉𝒐 𝑯𝒆̣̂ 𝑻𝒉𝒐̂́𝒏𝒈 𝑳𝒐̣𝒄
🌐 https://thietbilocmiennam.vn/
📞 0938.141.584 hoặc 0902710518
📩 miennamfilter@locmiennam.com
🔴Youtube: Công Nghệ Thiết Bị Lọc Miền Nam
📘 Facebook: CTy TNHH Công Nghệ Thiết Bị Lọc Miền Nam
📱 Zalo OA: Công nghệ thiết bị lọc Miền Nam